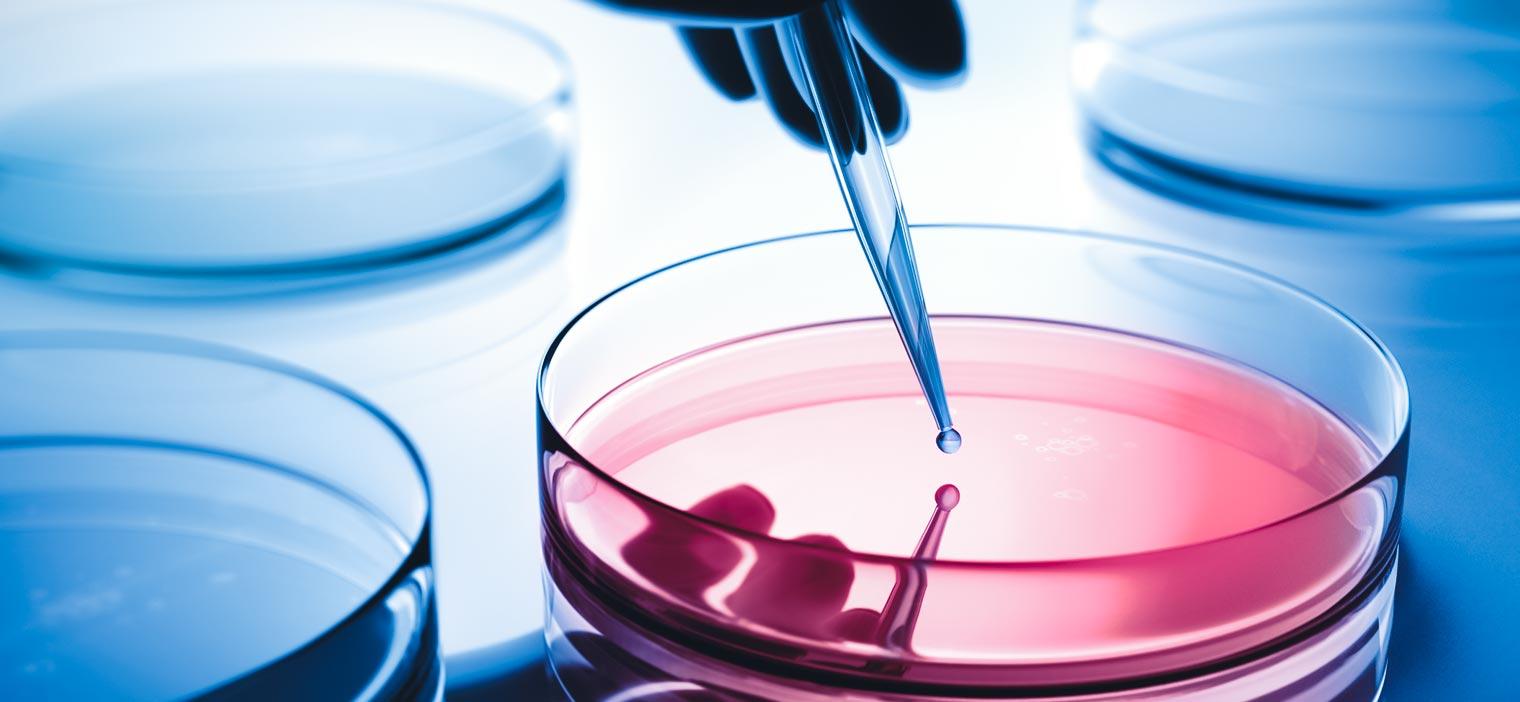

With specialized expertise and innate curiosity, today's science and research executives inspire others to follow bold visions.
WittKieffer identifies leaders at the nexus of academic medicine, healthcare, life sciences, and the private equity worlds. The scientific and R&D leaders of today are driving innovation, creating disruption, and building consensus around new ideas and technologies. Their work is crucial in shaping organizational strategy and identifying future opportunities and breakthroughs.